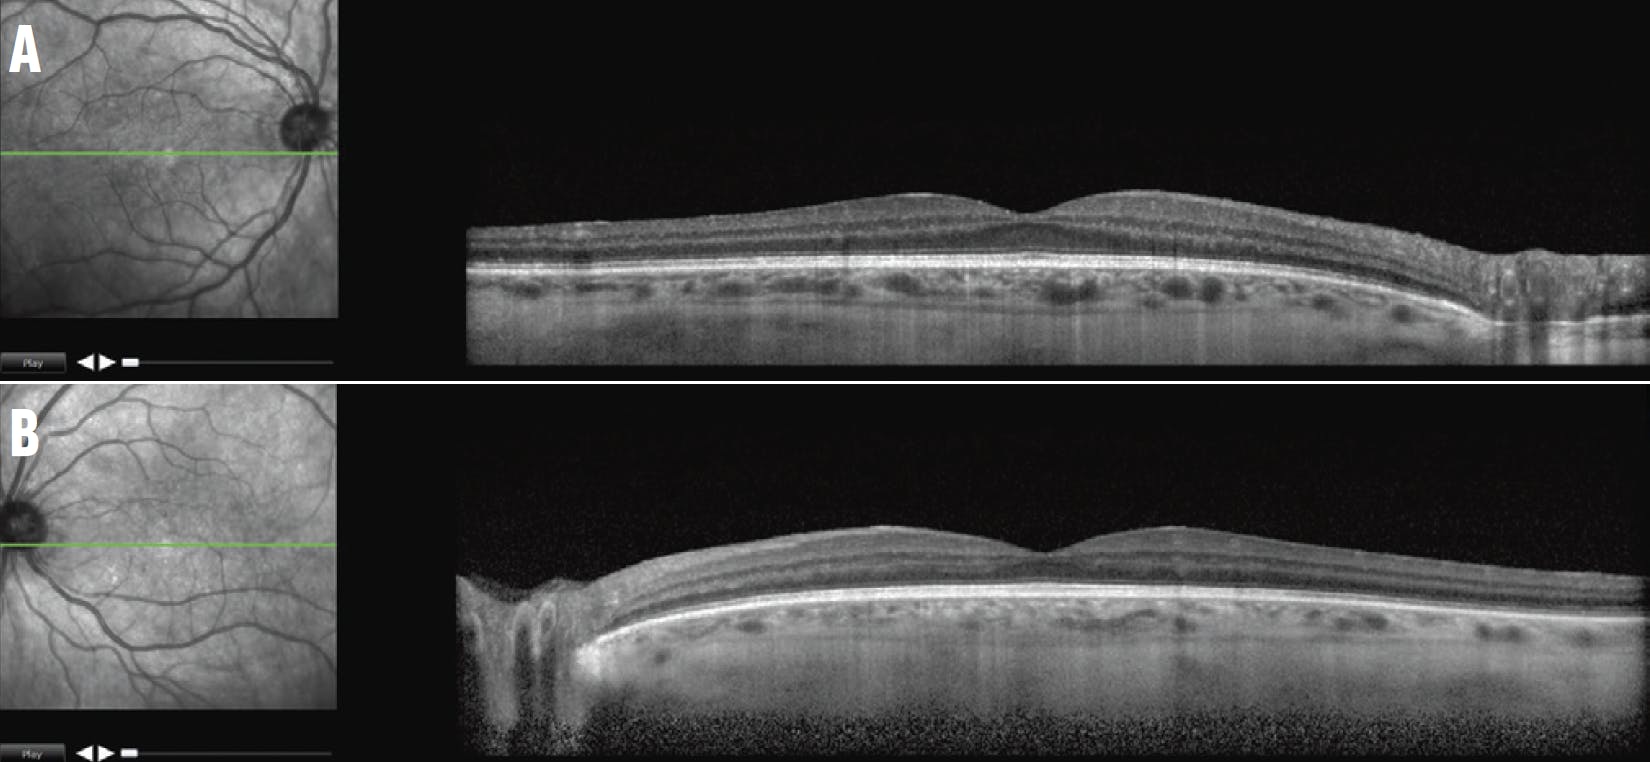

Systemic infection with Cryptococcus neoformans, a form of encapsulated yeast, occurs most commonly in immunocompromised individuals and is contracted via inhalation. The primary site of infection is the lungs, although ocular involvement can occur secondary to hematogenous spread or through the leptomeninges. Infection most commonly occurs in patients with human immunodeficiency virus (HIV)/acquired immune deficiency syndrome (AIDS).1-3 Ocular manifestations may include optic nerve involvement and papilledema.
Here, we report a case of primary bilateral serous choroidal detachments leading to the diagnosis of systemic cryptococcosis and HIV in a previously undiagnosed patient.
CASE REPORT
A 49-year-old White man presented with bilateral vision loss and numbness in his left arm. His ocular history was significant for bilateral cataract extraction at 9 years of age with aphakic correction until he underwent bilateral anterior chamber IOL (ACIOL) placement at 43 years of age. Further details of the cataract extraction were not known.
At presentation, his BCVA was 20/70 OD and 20/100 OS, and his IOP was 17 mm Hg OD and 20 mm Hg OS. The anterior chamber in each eye was deep and quiet, notable only for the ACIOLs. There was no vitritis or vitreous haze in either eye. Fundus examination of each eye showed moderate-sized serous choroidal detachments in the temporal and nasal periphery and multiple choroidal hemorrhages in the nasal periphery (Figure 1). B-scan ultrasonography confirmed the serous nature of the choroidal detachments and revealed a normal axial length in each eye (Figure 2).

Figure 1. Montage fundus photographs of the right (A) and left (B) eye at presentation showed choroidal detachments and choroidal hemorrhages in the nasal periphery.

Figure 2. B-scan ultrasound images confirmed the serous nature of the choroidal detachments in the right (A) and left (B) eye.
The patient reported recent unintentional weight loss of 20 to 30 lbs and serous drainage from a painful tooth abscess. He was immediately hospitalized for evaluation and workup for possible systemic infection or neoplastic process. Multimodal imaging with fluorescein angiography, ICG angiography, and OCT was not obtained at his initial visit due to the urgent need to address his systemic illness.
The patient was subsequently diagnosed with AIDS complicated by cryptococcal infection. His CD4 count was 69, and his HIV viral load was 350,000. Serum Cryptococcus antigen was positive, and a CT-guided biopsy of a cavitary lung lesion was positive for Cryptococcus by histopathology. Lumbar puncture and cerebrospinal fluid analysis were normal and did not reveal central nervous system (CNS) involvement. The patient was started on topical 1% prednisolone, topical atropine, and systemic induction treatment with intravenous amphotericin and flucytosine.
At his 1-week follow-up at our clinic, his BCVA improved to 20/40 OD and 20/30 OS. Fundus photography showed resolution of the choroidal effusions and choroidal hemorrhages (Figure 3), and OCT was unremarkable (Figure 4).

Figure 3. Fundus imaging at the 1-week follow-up visit showed complete resolution of the choroidal detachments in the right (A) and left (B) eye.
Figure 4. OCT at the 1-week follow-up visit showed normal macular retinal and underlying choroidal architecture in the right (A) and left (B) eye.
AN UNUSUAL PRESENTATION
Ocular manifestations of cryptococcosis have been described as a complication of systemic disease. Isolated ocular involvement due to hematogenous spread in the form of multifocal choroiditis or, rarely, endophthalmitis has been reported.1-3 Papilledema and ophthalmoplegia due to high intracranial pressure from CNS involvement of cryptococcus has also been described.4 In addition, uveal effusion leading to angle-closure glaucoma in phakic patients has been observed in patients with HIV/AIDS.5
Our case is unusual because the bilateral serous choroidal detachments were the presenting sign of newly diagnosed HIV/AIDS complicated by systemic cryptococcal infection, which, to our knowledge, has not been previously reported. Interestingly, our patient had a history of cataract extraction with ACIOL placement and presented with normal IOPs and deep anterior chambers, despite the moderate-sized serous choroidal detachments in each eye.
The pathogenesis of the choroidal detachments was unclear; however, the fact that his eyes were unicameral may have played a role. The mechanism leading to the serous choroidal detachments was likely multifactorial, involving the hematogenous spread of cryptococcosis and local ocular inflammatory, hemodynamic, and hydrodynamic factors.
KEEP YOUR GUARD UP
Ocular involvement with systemic cryptococcal infection occurs most commonly in the setting of severe immunosuppression. Optic nerve involvement and papilledema due to increased intracranial pressure and, less commonly, multifocal choroiditis are well-described ocular signs of systemic cryptococcosis, particularly among patients with HIV/AIDS. However, this case suggests the presence of bilateral serous choroidal detachments may herald the onset and raise the suspicion of this infection in the appropriate clinical context.
Early recognition of this finding may facilitate prompt diagnosis and treatment with subsequent preservation of visual function and reduced systemic morbidity.
Acknowledgment: Financial support was provided in part by an unrestricted grant from Research to Prevent Blindness to the Department of Ophthalmology and Visual Sciences, University of Utah.
1. Kestelyn P, Taelman H, Bogaerts J, et al. Ophthalmic manifestations of infections with Cryptococcus neoformans in patients with the acquired immunodeficiency syndrome. Am J Ophthalmol. 1993;116(6):721-727.
2. Baillif S, Delas J, Asrargis A, Gastaud P. Multimodal imaging of bilateral cryptococcal choroiditis. Retina. 2013;33(1):249-251.
3. Chen J, Chai C, Teoh SC. Cryptococcal-related exudative retinal detachment. Eye. 2011;25(9):1234-1235.
4. Battu R, Biswas J, Jayakumar N, et al. Papilloedema with peripapillary retinal hemorrhages in an acquired immunodeficiency syndrome (AIDS) patient with cryptococcal meningitis. Indian J Ophthalmol. 2000;48(1):47-49.
5. Nash RW, Lindquist TD. Bilateral angle-closure glaucoma associated with uveal effusion: presenting sign of HIV infection. Surv Ophthalmol. 1992;36(4):255-258.


















